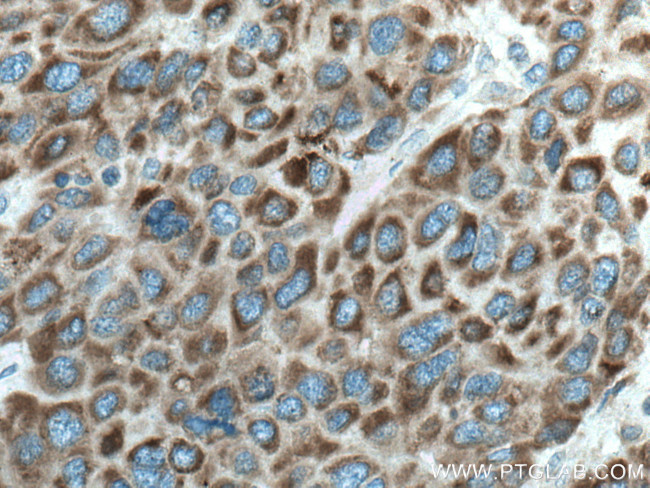
CYP27A1 Antibody in Immunohistochemistry (Paraffin) (IHC (P))

Search
Proteintech
CYP27A1 Monoclonal Antibody (3G3F7)
{{$productOrderCtrl.translations['antibody.pdp.commerceCard.promotion.promotions']}}
{{$productOrderCtrl.translations['antibody.pdp.commerceCard.promotion.viewpromo']}}
{{$productOrderCtrl.translations['antibody.pdp.commerceCard.promotion.promocode']}}: {{promo.promoCode}} {{promo.promoTitle}} {{promo.promoDescription}}. {{$productOrderCtrl.translations['antibody.pdp.commerceCard.promotion.learnmore']}}
产品信息
67045-1-IG
种属反应
宿主/亚型
分类
类型
克隆号
抗原
偶联物
形式
浓度
规格
纯化类型
保存液
内含物
保存条件
运输条件
产品详细信息
Aliquoting is unnecessary for -20°C storage.
靶标信息
CYP27A1 participates in the degradation of cholesterol to bile acids in both the classic and acidic pathways. [1] It is the initiating enzyme in the acidic pathway to bile acids, yielding oxysterols by introducing a hydroxyl group to the carbon at the 27 position in cholesterol. In the acidic pathway, it produces 27-hydroxycholesterol from cholesterol whereas in the classic or neutral pathway, it produces 3beta-hydroxy-5-cholestenoic acid. It is also involved in the metabolism of vitamin D3. While CYP27A1 is present in many different tissues, its function in these tissues is largely uncharacterized. In macrophages, 27-hydroxycholesterol generated by this enzyme may be helpful against the production of inflammatory factors associated with cardiovascular disease.
仅用于科研。不用于诊断过程。未经明确授权不得转售。
生物信息学
蛋白别名: 5-beta-cholestane-3-alpha, 7-alpha, 12-alpha-triol 26-hydroxylase; 5-beta-cholestane-3-alpha, 7-alpha, 12-alpha-triol 27-hydroxylase; 5-beta-cholestane-3-alpha,7-alpha,12-alpha-triol 26-hydroxylase; 5-beta-cholestane-3-alpha,7-alpha,12-alpha-triol 27-hydroxylase; cholestanetriol 26-monooxygenase; cholesterol 27 hydroxylase; cyt; Cytochrome P-450C27/25; Cytochrome P450 27; cytochrome P450, 27; cytochrome P450, 27a1; cytochrome P450, family 27, subfamily A, polypeptide 1; cytochrome P450, subfamily XXVIIA (steroid 27-hydroxylase, cerebrotendinous xanthomatosis), polypeptide 1; Sterol 26-hydroxylase, mitochondrial; Sterol 27-hydroxylase; unnamed protein product; Vitamin D(3) 25-hydroxylase
基因别名: 1300013A03Rik; CP27; CTX; CYP27; CYP27A1; P450C27
UniProt ID: (Human) Q02318, (Mouse) Q9DBG1, (Rat) P17178
Entrez Gene ID: (Human) 1593, (Mouse) 104086, (Rat) 301517